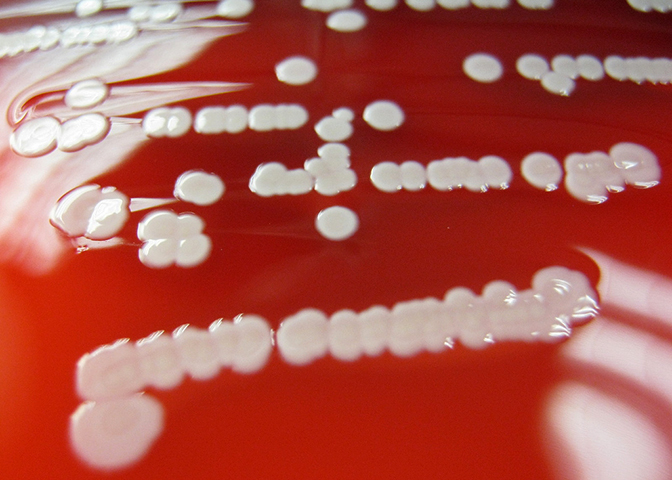

В природе обитают микроорганизмы, которые способны производить токсины, нарушающие жизнедеятельность клеток живого организма. Они могут разрушительно воздействовать на кожу, подкожную клетчатку и соединительную ткань, вызывая болезненные поражения и даже смертельный исход. Примером таких вредителей являются стафилококки.
Об особенностях стафилококковой инфекции
Этой микробной форме жизни известно примерно 50 видов. Все они проявляют различные уровни агрессивности и активности, выживают в различных условиях окружающей среды и обладают высокой устойчивостью к антибиотикам.
Стафилококковая инфекция может быть обнаружена на коже человека в любое время:
- В обонянии.
- В полости рта.
- На поверхности кожи.
Стафилококки могут вызывать различные опасные заболевания, такие как сепсис, токсический шок, пневмония, гнойные кожные заболевания, абсцессы в разных частях тела, проблемы с опорно-двигательным аппаратом, инфекции глаз, менингит, поражения опорно-двигательного аппарата (например, артрит или остеомиелит), перитонит, отравление пищей, нарушения центральной нервной системы, общую интоксикацию организма, а также осложнения после воспалительных заболеваний и хирургических операций.
Коагулазонегативный стафилококк: его особенности, вредное воздействие на человеческий организм
Во время специального исследования покровов тела здорового человека была обнаружена обширная группа бактерий, которые не представляют опасности для здоровья большинства людей. В большинстве случаев организм не подвергается инфицированию. Это свидетельствует о том, что наличие этих вирусов в микрофлоре кожи является нормой. Условная патогенность данного вида инфекции указывает на то, что такие стафилококки могут оказывать отрицательное воздействие на здоровье человека или животного только при определенных условиях.
В зависимости от способности вырабатывать коагулазу (фермент, который вызывает свертывание плазмы крови), такие стафилококки могут быть разделены на коагулаза-положительные (коагулазопозитивные) и коагулаза-отрицательные (коагулазонегативные).
Среди 5 известных типов коагулазопозитивных стафилококков особую опасность для здоровья человека представляют 3 типа: эпидермальный, сапрофитный и золотистый – наиболее распространенные возбудители заболеваний с гнойно-воспалительным проявлением.
Золотистый стафилококк
Госпитальные штаммы, которые активно распространяются в стационарных медицинских учреждениях, включают в себя группу стафилококков, не производящих коагулазу (коагулазонегативные). По результатам лабораторных исследований было установлено, что среди 20 известных видов коагулазонегативных стафилококков лишь несколько способны вызывать серьезные нарушения здоровья человека.
Их особенность заключается в высокой вирулентности (способности вызывать инфекционный процесс при благоприятных условиях) и устойчивости к антимикробным препаратам. К коагулазанегативным стафилококкам относятся менее патогенные виды, такие как эпидермальный, сапрофитный, Staphylococcus caprae и другие.
Staphylococcus caprae
Механизм действия стафилококков
Когда инфекция проникает в организм, она начинает ослаблять его. В результате этого процесса выделяется большое количество токсинов (ядов), которые:
- Портят функционирование клеток в организме.
- Сбивают их обычный ритм работы.
- Приводят к появлению различных заболеваний, особенно при ослабленной иммунной системе.
Часто стафилококковая инфекция возникает как осложнение других заболеваний. Особенно подвержены ей ослабленные пациенты:
- Люди, которые прошли продолжительное лечение антибиотиками.
- Пациенты с онкологическими заболеваниями.
- Маленькие дети.
- Люди в зрелом возрасте.
Об опасности инфицирования коагулазонегативным стафилококком
При изучении различных инфекций, вызванных коагулазаотрицательным стафилококком, можно выделить несколько характерных общих особенностей:
- Медленное прогрессирование с длительным скрытым периодом (за исключением быстрого развития бактериемии только у пациентов с нейтропенией).
- Госпитальные инфекции – источники этого возбудителя (за исключением инфекционного эндокардита и инфекций мочевыводящих путей, вызванных Staphylococcus saprophyticus).
- Практически все инфекции этого возбудителя устойчивы к большинству антибиотиков, включая пенициллины и цефалоспорины.
- Они часто связаны с имплантацией медицинских устройств и приспособлений. Этим вирусом легко заражаются венозные катетеры, артериовенозные шунты для гемодиализа, ликворотводящие шунты, катетеры для перитонеального диализа, протезы суставов, сосудистые трансплантаты и протезированные клапаны.
Справиться с проблемой последствий инфицирования, не удалив эти устройства, практически невозможно. Так медики и поступают, если есть возможность избавиться от имплантата. В случаях недопустимости такого действия, терапия антибиотиками – единственное решение проблемы.
Особенности возбудителя
Чаще всего, коагулазонегативный стафилококк обнаруживается в крови пациентов, находящихся в стационаре. Этот вид бактерий распространен в больничных палатах, операционных и других местах, где особое внимание уделяется чистоте и дезинфекции. Почему это происходит? Следует отметить, что возбудитель – основной элемент здоровой микрофлоры кожи. Медицинские инструменты, используемые при имплантации, могут быть заражены бактериями, которые принадлежат как здоровым членам медицинского персонала, так и самим пациентам.
Пояснение заключается в том, что корень проблемы – сниженная защитная сила организма пациента в больничной палате. Можно сделать вывод, что несмотря на невысокую опасность этих микробов, они активно размножаются в местах с большой концентрацией больных людей, у которых легко возникают инфекции из-за ослабленного иммунитета.
Люди с сильной защитой организма легко переносят инфекции, вызванные бактериями. Однако при сниженном уровне нейтрофилов у пациентов инфекция может привести к серьезному отравлению крови, что в некоторых случаях может быть смертельным.
Диагностика инфекций коагулазонегативных стафилококков
Ключевым фактором риска этого заболевания являются длительно находящиеся в организме инородные предметы (например, катетеры, шунты и другие). Поскольку бактерии могут прикрепляться к различным материалам, практически любые инородные предметы могут быть заражены. Это относится и к медицинским устройствам, которые вживляются у пациентов.
Определить наличие инфекции коагулазонегативных стафилококков с помощью лабораторных методов по первой пробе обычно вызывает определенные трудности.
Прежде всего, при анализе крови может быть обнаружена зараженная проба, а не бактериемия. Для получения точной картины проводятся исследования нескольких проб, проводятся повторные посевы, анализируются клинические признаки инфекции и учитывается наличие медицинского оборудования у пациента.
Во-вторых, важно отметить, что неэффективно тратить время на проведение повторных посевов у пациентов с нейтропенией. Задержка в этом случае критична – требуется предоставить неотложную медицинскую помощь.
Лечение инфекции
Для лечения таких инфекций, связанных с имплантированным медицинским устройством, часто достаточно провести удаление этого устройства. Иногда невозможно удалить устройство в целях поддержания жизни пациента, поэтому применяется курс лечения антибиотиками.
Для этой категории пациентов лечение в стационаре продолжается в течение определенного периода времени (до 6 недель). Оно также включает в себя необходимость применения дополнительных антибиотиков, что делает его значительно более затратным с финансовой точки зрения.
Еще одной проблемой является то, что часто применяемые для лечения антибиотики (например, ванкомицин) способствуют быстрому распространению микроорганизмов, устойчивых к их воздействию. Медики вынуждены применять сложные схемы и комбинации препаратов для достижения эффективности лечения.
Использование народных средств в борьбе с такими инфекциями имеет свою ценность. Укрепление иммунитета является надежным способом защиты от заболеваний, вызванных этими бактериями, поэтому не следует отказываться от такой возможности.
Эксперты советуют обогатить запасы народной аптеки растениями, которые способствуют укреплению защитных сил организма и быстрому восстановлению иммунитета. Присутствие эвкалипта, листьев подорожника, кипрея, женьшеня, лимонника, расторопши и других иммуномодуляторов в рационе не только для лечения, но и для питания, позволит поддерживать иммунитет в отличном состоянии.
Частые вопросы
Что представляют собой коагулазонегативные стафилококки?
Коагулазонегативные стафилококки (CoNS) — это группа бактерий, которые обычно обитают на коже и слизистых оболочках человека. Они отличаются от коагулазоположительных стафилококков и имеют способность вызывать различные инфекции, особенно у людей с ослабленным иммунитетом.
Каковы особенности инфекций, вызванных коагулазонегативными стафилококками?
Инфекции, вызванные коагулазонегативными стафилококками, могут включать в себя кожные инфекции, инфекции крови, инфекции мочевыводящих путей и другие. Они могут быть особенно опасны для новорожденных, пожилых людей и людей с ослабленным иммунитетом.
Каковы методы лечения инфекций, вызванных коагулазонегативными стафилококками?
Лечение инфекций, вызванных коагулазонегативными стафилококками, обычно включает в себя применение антибиотиков, чувствительных к этим бактериям. Важно проводить антибиотикотерапию под наблюдением врача и следовать всем рекомендациям для предотвращения рецидивов и осложнений.
Полезные советы
СОВЕТ №1
При обнаружении коагулазонегативных стафилококков необходимо провести антибиотикограмму для определения чувствительности к антибиотикам, так как они могут проявлять устойчивость к некоторым препаратам.
СОВЕТ №2
Важно соблюдать правила гигиены, особенно в медицинских учреждениях, чтобы предотвратить распространение коагулазонегативных стафилококков, так как они могут вызывать инфекции у пациентов с ослабленным иммунитетом.
СОВЕТ №3
Лечение инфекций, вызванных коагулазонегативными стафилококками, обычно включает применение антибиотиков, но выбор препарата зависит от чувствительности микроорганизмов к ним, поэтому важно следовать рекомендациям врача.